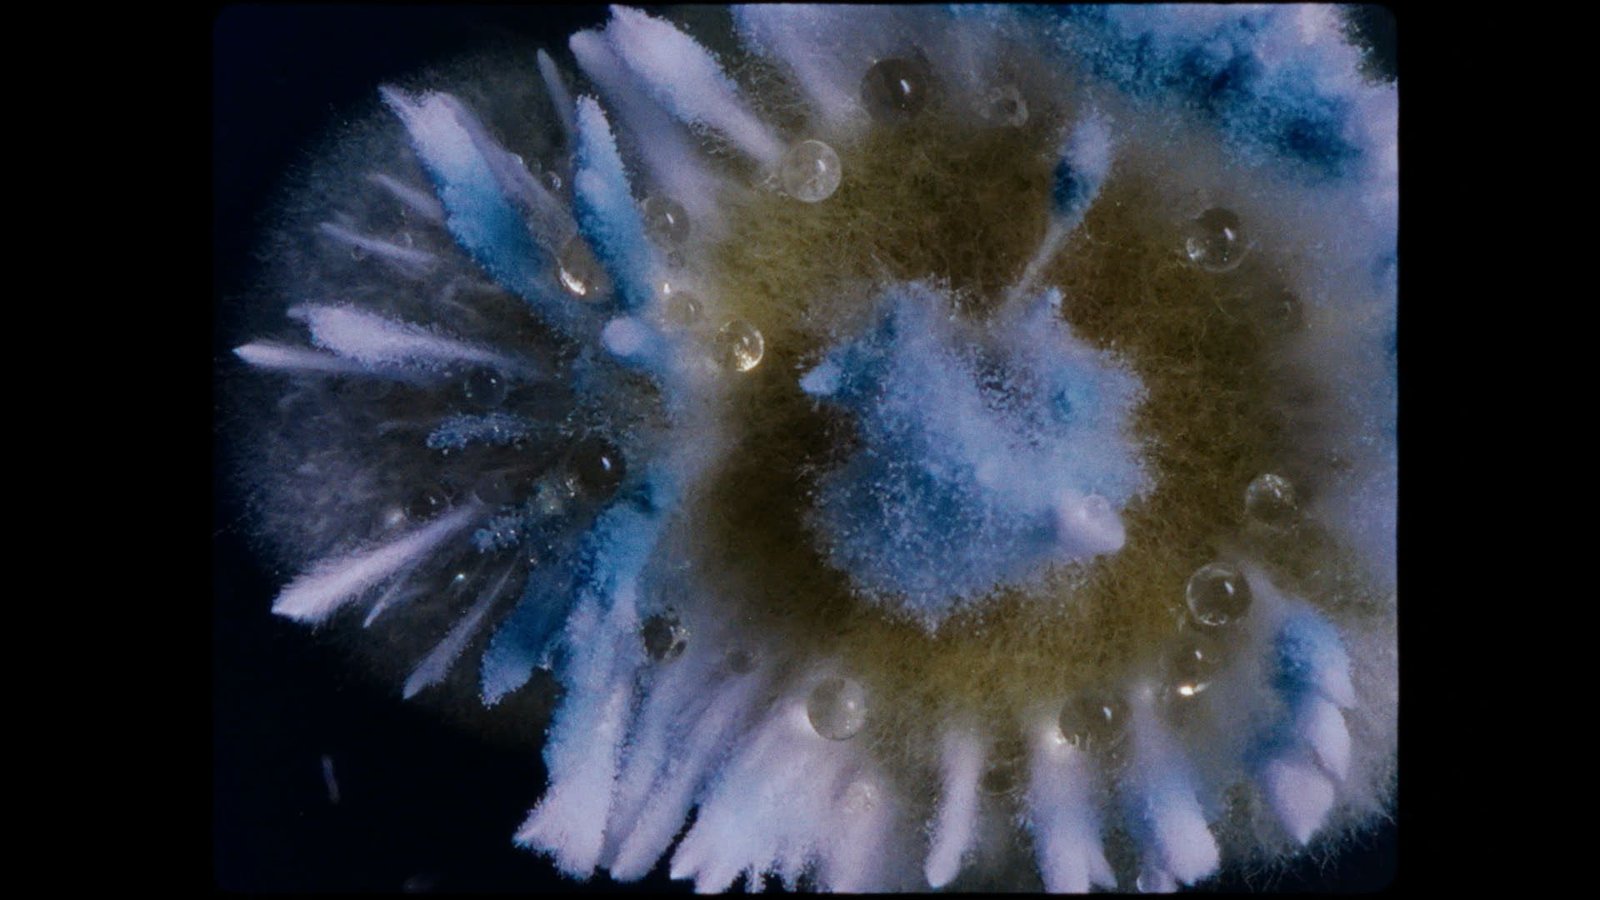

Filmo „Dulkės, kaulai ir stebuklai“ režisierė Aistė Žegulytė: kiekvienas suranda, kas jam amžina, o kas – laikina
„Man amžina tai, ko negali apčiuopti. Tai gali būti jausmas, prisirišimas prie objekto ar žmogaus žvilgsnis į meno kūrinį. Amžina tai, ko negali sunaikinti pelėsiniai grybai. O laikina – tai, kas mums nėra svarbu, man tai – materialūs dalykai“, – sako režisierė, meninės dokumentikos filmo „Dulkės, kaulai ir stebuklai“ autorė Aistė Žegulytė.
Nuo balandžio 10 dienos į Lietuvos kino teatrus atkeliaujantis filmas „Dulkės, kaulai ir stebuklai“ toliau renka festivalių apdovanojimus – neseniai pasibaigusiame „Kino pavasaryje“ filmas buvo išrinktas geriausia lietuviška premjera ir įvertintas Specialiu paminėjimu tarptautiniame konkurse. Amsterdamo dokumentinio kino festivalio (IDFA) konkursinėje programoje „Envision“ juosta apdovanota už geriausią režisūrą, o Talino „Juodųjų naktų“ kino festivalyje laimėjo geriausio dokumentinio filmo apdovanojimą.
Likus dviems savaitėms iki filmo premjeros Lietuvoje A. Žegulytė („Animus Animalis (istorija apie žmones, žvėris ir daiktus)“) papasakojo apie septynerius metus kurto filmo procesą, kaip susižavėjo restauratorių meistryste, kartu su mokslininku iš Edinburgo dr. Patrick Hickey fiksavo mikroskopinių grybų pasaulį ar su operatoriumi Vytautu Katkumi dvi savaites gyveno Valjadolide ir stebėjo vietinės brolijos gyvenimą, kad įamžintų šimtmečius trunkančią ritualinę procesiją.
Filme vieną iš pagrindinių vaidmenų atlieka restauratoriai, kurie naujam gyvenimui prikelia meno kūrinius ir mumifikuotus palaikus. Kaip ir kodėl jie tave sudomino?
Restauratoriai man yra lyg vedliai į praeities sluoksnius, istoriją, meno pasaulį. Jie padeda mums pažinti praeitį tiek menine, tiek kultūrine prasme. Mane sužavėjo, kad paveikslai turi sluoksnius ir darant rentgeną ar naudojant kitas fotografavimo technologijas, mes galime prasiskverbti į kitus nematomus sluoksnius, pamatyti, kaip paveikslas buvo pažeistas ar kaip dailininkas keitė jį kūrybinio proceso metu.
Restauracijos meistrai – nematomi stebukladariai, kurie savo kruopščiu darbu leidžia mums šimtmečiais grožėtis kūriniais ar objektais, mokytis iš meno, jį analizuoti. Jų indėlis į istorijos saugojimą – neįkainojamas. Iki šio filmo apie tai nebuvau susimąsčiusi.
Papasakok, kokie meno kūriniai ir netgi mumifikuoti palaikai restauruojami filme?
Mes pasirinkome tik vieną tapybos kūrinį – stebuklingą Švč. Mergelės Marijos paveikslą su kūdikiu, kuris po restauravimo buvo grąžintas į Krekenavos baziliką. Jį restauravo Janina Bilotienė, kuri prisidėjo prie visų taip vadinamų stebuklingųjų paveikslų restauravimo. Tokie paveikslai kabo Aušros Vartų koplyčioje, Šiluvoje. Fiksavome trejus iš septynerių restauracijos metų. Paveikslas buvo pažeistas pelėsinio grybo, tačiau ne itin stipriai.
Filme restauruojami ir mumifikuoti vyskupų Simono ir Juozapo Giedraičių palaikai. Žiūrovai išvys, kaip nuo jų paimama mikrobioma, siekiant išsiaiškinti, kokios grybinės kultūros juos pažeidė, o vėliau ir restauracijos procesą – kaip kaulai sudėliojami, kūnai perrengiami naujais specialiais pasiūtais drabužiais, batais, transportuojami ir grąžinami į palaidojimo vietą Varnių bažnyčioje. Šis filmavimas truko apie vienerius metus.
Bene labiausiai žiūrovų akis traukia mikroskopiniai grybai ir jų margaspalvis pasaulis. Kaip jie atsidūrė tavo kūrybiniame akiratyje, ką jie tau simbolizuoja?
Šiuo atveju grybai mano akiratyje atsirado anksčiau nei žmonės. Turbūt kaip ir žemėje jie atsiranda pirmieji. Kartu su filmo operatoriumi ir idėjiniu bičiuliu Vytautu Katkumi norėjome parodyti nenutrūkstamą gyvenimo ciklą, kuris neturi jokios pabaigos. Pagrindiniai šio proceso personažai yra biodestruktoriai, t.y. pelėsiniai grybai. Jais susidomėjome beveik prieš dešimtmetį filmuodami pirmąjį filmą „Animus Animalis (istorija apie žmones, žvėris ir daiktus)“.
Pradėjome tyrinėti, kokios rūšys auga, kokie jų charakteriai, kurie grybai atrodo vizualiai įdomiai ir patraukliai, ką jie mėgsta skaidyti, kaip dauginasi, kokia jų spalva, jautrumas drėgmei ir šviesai. Buvo daug kriterijų pagal kuriuos atsirinkinėjome pelėsinius grybus filmui.
Be to, pasaulyje tėra keli operatoriai, kurie specializuojasi mikroskopinių grybų filmavime. Vienas iš jų – mokslininkas dr. Patrickas Hickey iš Edinburgo. Susisiekiau ir Patrickas iš karto sutiko bendradarbiauti, vėliau prasidėjo eksperimentai su įvairiomis grybų kultūromis.
Pradžioje buvo dešimt grybų rūšių. Kai kurios rūšys buvo pavojingos, kaip pavyzdžiui, tokios, kurios auga ant faraono Ramzio mumijų ir yra nužudžiusios ne vieną kapų plėšiką. Įkvėpus grybų sporos greitai pasklinda po plaučius. Tokių nusprendėme neauginti. Tad filme liko keturi mikroskopiniai grybai, savotiški personažai, kurių charakterius paryškino Gedimino Jakubkos muzikinės kompozicijos: erotiškas ir pavojingas, mėgstantis maistą, kitas – dievinantis šviesą, trečias – atvirkščiai, vešintis tik tamsoje, ant bažnytinių paveikslų, o ketvirtas – pavojingiausias grybas, kurio sporų įkvėpimas net gali sukelti rimtas ligas.
Kiek truko grybų filmavimo procesas?
Kiekvienas grybas turi savo unikalų gyvavimo ciklą – nuo sporos sudygimo iki pasidauginimo ir naujos sporuliacijos. Norėjome užfiksuoti šį ciklą. Vienų grybų gyvavimo ciklas – 24 valandos, kitų – 4–7 paros. P. Hickey laboratorijoje yra didžiulė juoda dėžė, lyg pusė šaldytuvo. Atsidaro durelės, sienos apdengtos juoda medžiaga ir galima joje ruošti scenografiją, pastatyti ledines lempas, keisti fonus. Ten palikdavome kamerą, uždarydavome dureles ir stebėdavome kompiuterio ekrane, kaip grybai dauginasi. Juk svarbiausia netrukdyti grybams gyventi, jų nedirginti.

Dr. P. Hickey turi pilną šaldytuvą įvairių grybų sporų, tačiau kai kurias siuntėme iš Lietuvos. Tuo užsiėmė Gamtos tyrimų centro Biodestruktorių tyrimo laboratorijos mokslo darbuotoja dr. Jurgita Švedienė. Grybų sporos keliavo kaip mikroskopinė gyvybė – su antspaudais ir pasais, specialiose įpakavimuose, kad išliktų gyvos. Grybų filmavimai užtruko ketverius metus.
Filme užfiksuotos įspūdingos freskos ir kiti meno kūriniai. Kur juos atradote?
Mūsų vizijoje filmas buvo neįsivaizduojamas be „Danse Macabre“ („Mirties šokio“) freskos. Manoma, kad šis žanras išpopuliarėjo viduramžiais, po maro. Šie atvaizdai simbolizuoja amžinybę, laikiną mūsų kūną, statusą, kuris keliaujant mirties link nebėra svarbus. Išsiaiškinome, kad daug „Danse Macabre“ freskų yra Italijoje, Prancūzijoje. Norėjome, kad ji būtų senoje bažnyčioje, o ne eksponuojama muziejuje. Taip pasirinkome bažnyčią St. Germain, nedideliame Prancūzijos kaimelyje. Freska buvo 5 m aukštyje, tad operatoriui V. Katkui teko filmuoti užlipus ant pastolių.
Galerijų kūrinius taip pat rinkomės kruopščiai. Svarstėme keliauti arba į Paryžiaus Luvrą, Amsterdamą ar Berlyną. Norėjome mažiau žinomų kūrinių iš viduramžių, kad kadre labiau kalbėtų amžinumo, laikinumo tema, o ne atpažįstamo autoriaus braižas. Daugiau norėjome kūrinius stebinčių žmonių žvilgsnių, mezgančiais ryšį su vaizduojamu laiku. Nusprendėme pasirinkti Berlyno Gemäldegalerieekspoziciją.
Vedini savo vizijos, nukeliavote ir į Valjadolidą, kur ne vieną šimtmetį vyksta Didžiosios savaitės procesijos.
Religinę procesiją Semana Santa Valjadolide pirmasis pamatė V. Katkus. Kai atsiuntė man trumpus vaizdo įrašus, supratau, kad tai puikiai įsilies į filmą. Šis teatrališkas ritualas Ispanijos mieste vyksta jau kelis šimtmečius, pritraukia tūkstančius žmonių ir atskleidžia žmonių gebėjimą kurti ir tęsti tradicijas. Čia individas nebesvarbus, veikia žmonių bendruomenė. Semana Santa į gatves pritraukia begalę žmonių.
Pradžioje rašėme vietos brolijoms laiškus – su prašymu pas juos apsistoti porai savaičių. Galiausiai viena brolija atsiliepė ir pakvietė atvykti. Valjadolide gyvenome dvi savaites, stebėjome brolijos gyvenimą, rinkomės lokacijas, ruošėmės tūkstantinės eisenos filmavimui iš balkonų.
Procesijos vyksta kasdien, daugiau nei savaitę prieš Velykas, iki pat Didžiojo penktadienio. Kiekviena brolija turi savo giesmes, neša tonas sveriančias skulptūras ir taip pasitinka Velykas.
Kaip tau pavyko sujungti tokius skirtingų sričių meistrus kaip operatorius Vytautas Katkus, kompozitorius Gediminas Jakubka, mikologas profesorius Patrickas Hickey, mokslininkė Olga Ščit-Latonienė, antropologas dr. Rimantas Jankauskas?
Nežinau, ar čia likimas, ar čia užsispyrimas. Kaip didžiulę gyvenimo dovaną priimu tai, kad galėjau dirbti su tokiais talentais. Su V. Katkumi kūrybinė draugystė užsimezgė dar nuo studijų laikų, tai jau antrasis filmas, prie kurio dirbame kartu. Jo smalsumas, idėjos, vizijos visuomet suteikia didžiulį kūrybinį džiaugsmą. Kartu sugalvojome, kad kūrinio dalį filmuoti ne kaip įprastai, stačiakampyje, o apskritime – savotiškame amžinybės rate, be kampų. Taip suteikti žiūrovams tiek nuostabos, tiek atradimo jausmą.

Šio filmo kūrimas buvo labai daugiasluoksnis, o filmo idėja, netikėtumas, įdomumas ir subūrė smalsius kūrėjus, kuriuos intrigavo, kaip viskas atrodys. Man pačiai svarbiausia būti labai nuoširdžiu komandoje ir su žiūrovais, bei tikėti tuo, ką darai, t. y. tikėti ir mylėti kiną.
Ką palinkėtumei filmo žiūrovams?
Kviečiu ateiti atvira širdim, pasiduoti smalsumui ir kartu patirti filmo kelionę per visus laiko, tikėjimo, ieškojimo sluoksnius. Surasti savo kino stebuklus, kurie atsiskleis per mūsų asmeninius pojūčius ir patirtis. Tikiu, kad kiekvieną žiūrovą kino kalba nuves ten, kur ir reikia, ir kvies pačiam sau atsakyti, kas yra amžina, o kas laikina.
Filmą „Dulkės, kaulai ir stebuklai“ platina „Lokys, liūtas ir šakelė“, prodiuseriai – lietuvių „Studio Uljana Kim“ kartu su Prancūzijos kompanija „To Be Continued“ ir latvių „Studio Locomotive“. Filmo gamybą finansavo Lietuvos kino centras, Prancūzijos nacionalinis kino centras CNC, Latvijos nacionalinis kino centras bei Lietuvos nacionalinis radijas ir televizija. Filmo viešinimą dalinai finansuoja Lietuvos kino centras.